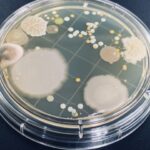

院長さん必見!!クリニックに水槽を置くべき理由

「新たにクリニックを開院したい!」
「新しい患者さんを獲得したい…」
「患者さんに選ばれるクリニックにしたい!!」
院長先生、こんなことを考えていませんか?
東京・大阪など都市圏のクリニックでよく導入されている水槽、なぜ導入されるのか?そのメリットは?? これについて解説させていただきます!
クリニックに水槽が置かれる理由とメンテナンス業者に依頼するメリットまで理解できますよ!
※長くなるのでぜひ目次も活用してください!
患者さんから見て「病院の水槽のイメージって?」
患者さんからするとクリニックの水槽はどう思われているんでしょうか?
まずは患者さんの思考を考えてみましょう。
院長さんが趣味でやってるんでしょ?
多くの患者さんはそう考えています!
都市圏ではメンテナンス業者が多いので業者が入っているのを知ってる方も増えますが、地方ではまだまだ少ないです。
そのためほとんどは「院長さんが好きで管理している」「スタッフさんがお世話をしている」と考えています。
キレイに管理されていれば「院長さんの腕がいいんだろうなぁ~」と好印象を持つでしょう!
しかし汚いと「管理の腕が悪いのかな…?」「忙しくてお世話できてないんだろう…」と思われる可能性が。
特に悪いパターンだと「生き物を大切にできない人なのか?」「水槽を見る患者のことを考えられない」とマイナスイメージを持たれてしまうことも…これは絶対に避けたいところですね…
水槽があるとオシャレなクリニックな印象になる!
無機質な待合室より、水槽があると華やかに見えます!
インテリアとしての水槽はオシャレなイメージも付き、キレイなクリニックという意識を持たれやすいです!
水槽を導入しているクリニックは四国ではまだまだ少ないです。金魚の水槽があるクリニックは目にしたことが多いかもしれません、でも海水魚の水槽となるとさらに少ないでしょう。
それはつまり、他のクリニックにはない差別化ポイントになるんです!!

海水魚の水槽ってけっこうお金かかってるのかな?
「海水魚水槽はお金がかかるんだろうな?」というイメージを持ってる人が多いでしょう。
事実お金がかかるゆえにまだまだ普及してない事情がありますので…
しかし裏を返せば、「患者さんをリラックスさせるためにそれだけ費用をかけているクリニックなんだ!」という印象を与えることだって可能でしょう!
一度導入したらずっと状態をキープできるものでしょ?
「エサやりや水換えの手間はあるけど、それさえやってればずっとキレイな状態を維持できるんでしょ?」と思ってる方が多いかも…
「病院の仕事しながらでもキープ出来てるんならわりと簡単なのかも?」と思う方もおられるかもしれません。実際は業者にお任せなのでクリニックの負担はほぼ無し!ってのがカラクリだったりするんですが…笑
水槽の状態って、コケ汚れの掃除や水換えをしてればOK・魚もずっと元気!…というほど簡単じゃないんです。海水水槽はそれが特に顕著かも…
例えば水槽内の岩、ちゃんと見たことあるでしょうか?「灰色一色だったけど、岩だしそんなもんかな」くらいの感想かもしれませんが、もし灰色一色の岩ならそれは状態が悪いと言わざるをえません…

メンテナンス業者が院長に勧めたい『クリニックの水槽のオススメポイント!』
クリニックに水槽が置かれることが多いのにはちゃんとしたオススメポイントがあるんです!
「お医者さんはお金があるから」とか「待合スペースが置くのにちょうどいいから」みたいなやらしい理由じゃない、クリニックさんと患者さんのためになるメリットをご紹介させてください!

クリニックと水槽の相性はバツグンに良い!
水槽って鑑賞する=眺めるものなので、「待ち時間がある業態」との相性が良いんです!
待合室にはTVや雑誌を置いてるクリニックさんは多いです。患者さんが少しでも退屈しないように考えて置いていただいてますよね?
こっちの方が水槽よりはお金はかからないのは確かですが、退屈しのぎだけじゃなくリラックスもできるのが水槽の魅力。魚たちの不規則な動きは見る者の目を惹く最適なツールです!
診療時間のTVはどうでしょう?患者さんが楽しめる番組は流れてるでしょうか??
雑誌はどうか?患者さんが興味ある雑誌は揃えられているでしょうか??
意外と患者さんのニーズを満たすのは難しいものだったりもしますよね…

患者さんをリラックスさせるのに最適!
クリニックの待合室、けっこう緊張してしまう患者さんは多いですよね。
特に歯医者の治療の待ち時間は「痛くないかな…」と感じて不安になる方は多いはず。
そんな患者さんにこそ水槽=アクアリウムが良いんです!
「アクアリウムの観賞はリラックス効果がある」という研究は世界中で報告例があるんですよね。
国内でもアクアリウム用品の大手メーカーと大学・研究機関の共同研究で発表がされています。その一例をご紹介↓
今までの「なんとなくリラックス効果がありそう」から、科学的根拠が示されてきているのがアクアリウムです!
コストの見える化も!
メンテナンス業者を利用するメリットとして『コストの見える化』があるんです!
水槽を置いているとエサ代・消耗品の交換・水換えの人工海水など…なにかとランニングコストが必要。
事業を運営するにはこういった費用は毎月固定化できた方がいいものです。
メンテナンス業者に依頼しておけばそのあたりの費用を定額料金で固定化・見える化ができるようになります!
月額料金とは別途の項目もありますが、どこまでの作業を料金に含めるか、よく相談してみてください!
定期的な管理でクオリティを維持しやすい
海水魚水槽の状態を維持していくのは定期的なメンテナンスと技術、手間と腕が必要。
自分で管理しているとメンテナンスのために予定を作らないといけませんが、これが突然の予定などで思いのほかうまくいかないことも…
そういった作業にリソースを割くのは止めてメンテナンス業者に投げてしまいましょう。そうすれば本業に集中できます!

水槽があるクリニックと無いクリニックの違い
都市部のクリニックでは導入が多い水槽。
メンテナンス業者のサービスも活用して『選ばれるクリニック』を目指しましょう!
系列のクリニックに複数置いていただく院長さんもいます。
ここで水槽があることのメリットを整理してみますと
水槽があることで得られるメリット
【ファミリー層の利用者にオススメできる】
お子様からの評判は絶大です!
待合室で水槽を眺めている間ジッとしててくれるのは親御さんとしてもクリニックとしてもありがたいです!

【キッズスペースの充実】
キッズスペースがあるクリニックも多いですが、そこに水槽を置くことでお子様からの評判も高まること間違いなしです!
スペースのレイアウトを考える際もパーテーション代わりに水槽を置くこともできますよ。

【患者さんの待ち時間のストレス軽減】
混みあってる待合室、水槽を眺めていれば長い待ち時間のストレスも軽減されます。
【覚えてもらいやすい】
なにせ覚えてもらいやすいです!水槽内に特徴的な魚が入っていればなおさら!
院長さんのクリニックの印象は「キレイな水槽が置いてあるクリニック」として長年愛される医院として記憶に刻まれるんです!
【代々に渡って愛されるクリニックへ】
ファミリー=お子様連れに好評というのは、そのお子様が成長してお子さんに恵まれた時に「小さな子どもがいてもあのクリニックなら安心だ!」と思ってもらえる可能性が高いです!
親から子へ、子から孫へ…患者さんが次世代へアナタのクリニックの魅力を伝えてくれるので、地場で末永く愛されるクリニックになっていくことでしょう!
コストを固定化してラクラク運用
メンテナンス業者に依頼すればだいたい月額料金は固定化できます。
費用は固定化してコストのコントロールを簡潔に!
作業は業者にお任せして時間も節約しちゃいましょう!
患者さんもスタッフさんも楽しめる!”水槽を育てる”という奥深さ
水槽は患者さんが楽しむだけではありません、スタッフさんの楽しみにもなります!
水槽が患者さんとスタッフさんの会話を生み出し、良好な関係作りの一端になることは多いんです!
水槽は設置した時が美しさのピークではありません。
長く維持していくことで熟成され、新しい水景を見せていくものです。
久しぶりに来院した患者さんが新しい魚やレイアウトを見て新たな気持ちで待合の一時を楽しんでもらえれば幸いです。
クリニックで水槽を置かれたお客様の実例・お客様の声
私は以前関東の大手水槽メンテナンス会社に勤め、多くのクリニックさんの水槽に携わりました。
その時にお聞きした実例や声をご紹介させていただきます!
新規患者獲得に役立ってよかった!
新規で開院するクリニック、新しい患者さんを呼び込むのはかなり難しいという話を聞きました。その時に水槽があることでキレイな印象が付いたことで、患者獲得の効果を実感していただけました!
関東はクリニックが山ほどありますが、病院もいまや多くは赤字経営と聞きました。
「医者=お金持ち」が一般的な印象ですが、そうでもない厳しい現実を聞きました…
地方になると昔からあるクリニックさんが周辺の患者さんを持っているので新規のクリニックが新たに患者さんを獲得するのは至難になっていると言えます…
そのお客様は周辺クリニックに水槽があるとこは少ないということで導入したところ、比較的若い層の患者さんから好評だったそうです!
他にもHPの紹介写真のネタ作りにも役立ったとか。
患者さんが病院を探す時に写真も重視するようで、その中に水槽がある待合室の写真を入れると候補に入りやすいようですね。
手間が減って仕事もプライベートもバランスがとれるように!
このお客様は自分がアクアリウムが好きで、経営しているクリニックに水槽を置いて自分で管理していました。
知識がある方でしたのでメンテナンスは問題無かったのですが…診療業務が終わった後に自分で水槽メンテナンスをするので、海水を作ってガラス面を掃除して…と時間をかけてやっていました。
そうすると夜の7時に帰れるところが9時とか10時になってしまうことも…
学会などの予定が入るとメンテナンス予定がズレますし、忙しいからと後回しにしすぎると汚くなって患者さんに見せられない状態になるのでそうもいかない…
と、自分で管理している時は大変だったそうです。
その後メンテナンス業者に依頼することで夜の水槽残業を無くし、他の仕事に時間を当てたり家族との時間を増やせるようになりました。
結果として月数万円で自分の時間を買ってよかったとのことでした!
【失敗例】節約のため自己管理をしたが…逆にマイナスイメージに
こちらのお客様は「メンテナンスに数万円なんてもったいない!」ということで自分で管理してましたが、知識の不足や忙しさでメンテナンスができずに水槽をキレイに維持できなかったようです。
そして患者さんから「水槽の魚、あんまりキレイじゃないね~」と言われてしまって…このままではイカンということでメンテナンス業者に依頼をいただきました。
幸いスタッフさんに言っただけで終わりましたが、これがネットの口コミに書かれるとかなりバツが悪いです…
無理に節約しようとして悪評がついてしまうと逆効果になる危険もあります。
院長自身の時間も水槽の質も、メンテナンス業者に丸投げして解決したほうがいい事例もありますよ!
【失敗例】思うように水槽搬入が進まなかった
開院に水槽が間に合わなかった、という事例も…。
水槽オーダーってすぐできると思われてる方が多いんですが、オーダーメイドだと1~2か月くらいかかると思った方がいいです。(工場の受注混み具合や、海外からの資材調達で時間かかることも…)
相談いただいたのが開院1か月前で納期がギリギリ間に合わなかった…というパターン。
なので開院後に搬入したんですが、これまたサイズが微妙に合わずにスペースにはまらないというトラブルも…これは院長-内装業者-メンテナンス業者の連携がうまくできてないことで発生した事例なのでメンテ業者にも多少落ち度はあったんですが…
結局別の既成水槽セットで妥協という形になりました。
水槽の導入を考えられてる時は早めに相談しておくことをお勧めします!相談段階で料金が発生することはあまりないので…
水槽導入を考えるときに注意したいポイント
最後に水槽をお考えになるときに「ココはよく確認しよう!」というポイントをご紹介します。
どのメンテナンス業者を選ぶか~設置例を確認してみよう
業者によって得意な分野があります。水草水槽が上手とか、低価格が売りとか…。
HPやSNSに設置事例をあげてあるので、それを見てどんな水槽を導入したいか?を考えてみてください。
ちなみに弊社は海水水槽を得意としています!海水なので価格は安いとは言えませんが…関東で2000回以上はメンテナンスした経験には自信があります。
良ければ設置事例にあたる「Photo Gallary」も見ていってください。
月額料金の中でどこまで作業をするのか?
作業内容はちゃんと打ち合わせの時に確認しましょう!
そして「別途料金がかかる項目はどれか?」も確認しておくべき。
しかし「作業を全部把握してないから質問のしようがない…」とお困りになる方も多いかも…
契約する時に書面にだいたい記載をしてくるものですが、そこを丁寧に説明していただける業者かどうかが良し悪しに関わってくるかもしれません。
それと「機材の交換頻度」も確認するのをお勧めします!
1年で交換すべき機材や部品があったりするんですが、それを知らずに契約してから1年後に「こちら別途で交換なので〇千円」とかいうパターンもあるんで…
たとえば弊社は「機材の交換」「魚の追加代」は別途としています。「水質検査」は込々だったり別だったりです…
魚の追加も定額内でしたいところですが…長くなるので割愛。ですが金額内である程度追加できるプランも構築できるので、そこは相談していただければ。
設置場所の確認
【窓際は避けよう】
直射日光が当たる場所は爆速で汚れますし温度管理もめちゃくちゃになります。
「窓に置いて中からも外からも見えるようにしたい!」という方は多いですが、絶対避けた方がいいです。
【空調管理ができる部屋】
日本の夏は暑すぎます…水槽用クーラーだけでは間違いなく維持できないです…
水槽用クーラーはイメージで言うと「室外機一体型」のクーラー。なので室内が高温だといくらクーラーが稼働しても温度が下がりません!!そのため空調管理も必要になるんです。
そのため夏期シーズンは24時間空調を覚悟しましょう。水槽用クーラーがあるなら室温設定は26~28℃くらいでもいいので…
そしてよくある失敗が「エントランスに置いて失敗」というパターン。
エントランスも空調が効くのならいいですが、ウェルカム水槽としてエントランスに置いたが、室内~屋外の間なので空調が入っておらず、夏場になって魚が死んでしまう事例がありました…
【耐荷重】
クリニックなら基本的には大丈夫ですが、水槽は重いので置く場所の耐荷重を確認しておきましょう。
床下配線が通っている場所は要注意です。
【水場の確認】
メンテナンスではほぼ間違いなく水場をお借りすることになります。
業者が入っている間使用できる水場はあるでしょうか?
お湯も出せる水場だとベストです。
【電源の箇所】
水槽は必ず電源が必要になります。水槽を置く場所の近くにコンセントはありますか?
近くに無くても延長して引っ張ってこれるかどうか確認しましょう!
【電源機器の配置】
水に弱い機器は近くにありませんか?特に床下コンセントは無いですか??
水槽はどんなに注意して管理しても地震で水が飛び散ったりすることはあります…!
その時に漏電の危険があるような箇所は避けるようにしましょう!
(水槽の下に水漏れ防止の受け皿を置く事例もあります!)
作業時間について
【メンテナンスに掛けられる時間】
ほとんどのクリニックさんではお昼の休診時間に作業を行います。
水槽規模によっては休診時間ではメンテ不可能なものもあったりします。
アナタのクリニックで運用できる規模の水槽かどうか、よく業者と相談して決めましょう。
【メンテナンスに使える日数】
メンテナンス業者が来ても大丈夫な日はあるでしょうか?
「お昼の休診時間には来客が多くてメンテナンス業者を入れられなかった」
「休診日に来てもらうようにしてたが、別の仕事が多くて立ち会えないのでメンテナンスできない」
こういった事例もありますので。
地方ではまだまだマイナーな”水槽メンテナンス業者”という存在。
クリニックさんが我々メンテナンス業者を利用するメリットをご紹介させていただきました。
「まだ踏ん切りは付かないけど、問い合わせだけしてみようかな…?」という方のご連絡も歓迎です。
院長さんの想いや悩みをお聞かせくださいませ!